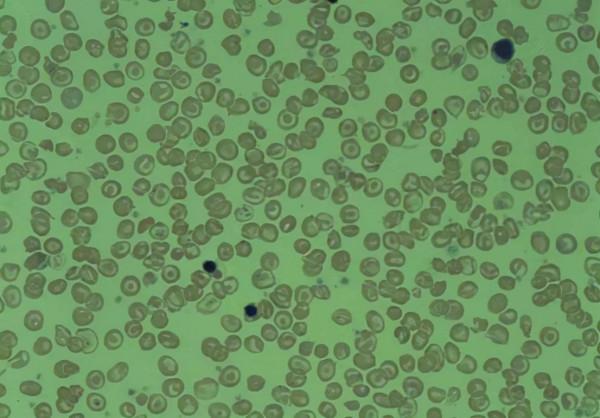
這是得了什麼病?美國女子熱衷吃牆皮,7年竟吃掉100多平方米 這是得了什麼病?美國女子熱衷吃牆皮,7年竟吃掉100多平方米

根據報道,在美國密歇根州,有一名奇怪的女子,過去的7年時間裡,這名女子最喜歡的食物,竟然是“牆皮”,而且已經累計吃進肚子裡100多平方米的牆皮。
據稱,這名女子原本並沒有這個特殊習慣,但是自從7年前接觸到了粉筆之後,她突然就對牆皮和粉筆的味道,產生了濃厚的興趣,特別是5年前,這名女子的母親去世,她本人也因為一些不順心的事,陷入到巨大的焦慮之中。
這個時候,她開始大量吃牆皮,而且奇怪的是,只要吃了牆皮,這名女子就會覺得非常放鬆,整個人也變得非常愉悅。
如今,這名女子基本上每天都需要吃牆皮,而且進食量也在不斷增加,對此,很多人都擔心她的健康問題,不過,透過醫院檢查,儘管吃了7年的牆皮,這名女子卻仍然非常健康。
那麼,為何這名女子會吃牆皮?這究竟是一種什麼病?
對於正常人來說,是絕對不會去想要吃牆皮的,顯然,這名美國女子每天大量食用牆皮,是因為她患上了某種特殊的疾病,而這種特殊的疾病,就是“異食癖”。
什麼是異食癖呢?簡單來說,就是患者會去吃一些不屬於食物的,或者是根本就沒有任何營養的物質,一般以吃紙片、泥土等居多。
在過去,人們曾經一度認為,患有異食癖的人,是因為體內缺少某種微量元素,從而透過食用非正常的食物來進行補充,不過,多年來的研究卻顯示,事實上異食癖屬於心理疾病的一種,因為患者普遍都是由於心理因素導致的。
就好像是這名美國女子,她是因為過度焦慮無法排解,從而導致患上了異食癖,最終透過吃牆皮,來進行自我解壓。
值得一提的是,在生活中,異食癖事實上並沒有那麼罕見,比方說在美國,曾經有一名女子因為失戀無法緩解,後來發現吃肥皂可以緩解,竟然每週都要吃至少5塊肥皂,才可以讓自己變得開心。
此外,在英國,還有一名女子因為懷孕壓力大,竟然開始吃一種化學制劑,而且明知道這麼做,胎兒會畸形,卻仍然控制不住自己,躲避著家人悄悄吃。
在我國,也有著這樣的情況,比方說在2019年的時候,有一名8歲的小女孩因為吃了太多的頭髮,導致身體出現嚴重問題,並且最終進入了ICU搶救。
可以說,患有異食癖的人,他們吃的東西都是千奇百怪,而且異食癖的發病,是不分年齡限制的,從兒童到老人,都是可以隨時發病的。
那麼,幾歲兒童出現異食行為,是屬於異食癖呢?
相信很多家裡有孩子的朋友,在孩子2歲之前,都會發現孩子會往嘴裡放一些不屬於食物的東西,那麼,是不是這樣的孩子,就是患有異食癖呢?
其實大家不需要擔心,因為在2歲之前,如果孩子出現了異食行為,是不屬於異食癖的,但是,如果過了2歲,仍然發現類似的異食行為發生,這個時候,就要去檢檢視看,孩子是否患有異食癖了。
比方說,在重慶就曾經有一個5歲的小男孩,從1-2歲的時候,就喜歡吃泥巴,一開始家裡人也沒注意,後來伴隨著年齡的增長,發現這個孩子吃泥巴越來越多,結果送到醫院檢查,最終被證明是患有了嚴重的異食癖。
那麼,異食癖又該如何治療呢?
異食癖的成因,其實是很複雜的,研究認為,除了心理因素之外,應該還有其它方面的原因,但是,目前科學界對於異食癖的研究,卻並沒有太大的進展。
也有研究者認為,或許一些異食癖患者,的確是因為生理原因引起的,簡單來說,就是身體缺少某種營養,比方說上文中提到過的,重慶那個喜歡吃泥巴的小男孩,後來身體檢查發現,他患有嚴重的地中海貧血,而且營養不良。
所以,目前的主流觀點,仍然認為兒童如果出現了異食癖,那麼,往往是與身體缺少某種微量元素有關,或者是營養方面的問題,是需要進行檢查和對症治療的。
而對於成年人來說,異食癖的出現就要更為複雜了,大部分都是心理因素為主,這也是很難治癒的,很多成年人患有異食癖,都會長達數年的時間無法治癒。
而且長期攝入異物,也會對身體造成嚴重的影響,因此,如果大家發現自己出現了此類的問題,或者是周圍人出現了異食癖前兆,千萬要立刻尋求治療。